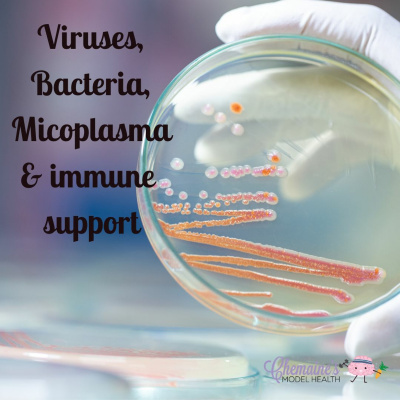
Find Your Model Health!

Find Your Model Health!
#149 Bacteria, Viruses, Micoplasma & the immune system
- Autor: Vários
- Narrador: Vários
- Editor: Podcast
- Duración: 0:31:32
- Mas informaciones
Informações:
Sinopsis
In this weeks episode we look at what viruses and mycoplasma are and how we can specifically target them with natural and herbal medicine, while also boosting our immune system. This is a resource that can be used all year round for many illnesses - not just targeted at the current coronavirus. Taking a good defensive or preventative approach can help us prevent future infections, conditions and complications. Please share with anyone you feel may benefit and it would mean the world to me if you could take a few minutes to leave a review, but only if you feel its deserved of course. :)